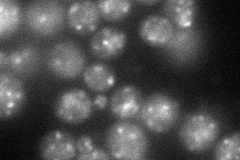
YML115C
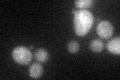
YML115C

View description
Component of the mannan polymerase I, which contains Van1p and Mnn9p and is involved in the first steps of mannan synthesis; mutants are vanadate-resistant
Localization:
Intensity:
Fold change:
Significance:
-
C’ GFP library in SD

punctate30.99 -
N' NOP1pr-GFP in SD
punctate78.375 -
N' TEF2pr-mCherry in SD

below threshold0 -
N' NATIVEpr-GFP in SD

punctate43.3022 -
N' TEF2pr-VC and Cyto-VN in SD

punctate32.7942 -
C’ GFP library in SD+DTT
punctate22.370.72Yes -
C’ GFP library in SD+H2O2

punctate26.510.85No -
C’ GFP library in Starvation Media

punctate21.460.69Yes -
C’ GFP library on the background of Pup2-DaMP

punctate -
C’ GFP library on the background of CCT mutant

punctate26.57630.857568No
